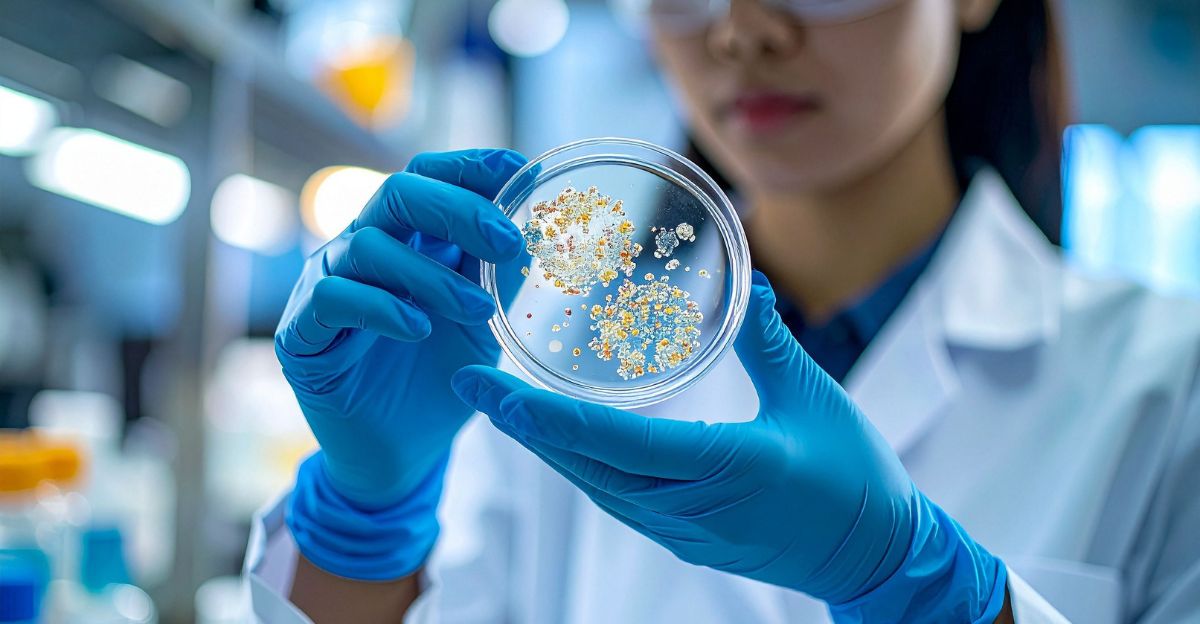

Desert rocks across two continents hold microscopic secrets that have puzzled geologists for over a decade.
Tiny tube-like structures, barely half a millimeter wide, honeycomb through ancient marble and limestone in unexpected patterns.
Their discovery challenges conventional understanding of what built them—and why they’re arranged so deliberately. Scientists now race to identify the architect behind structures older than human ancestors.
The Scale Becomes Clear

The tunnels span an area larger than previously imagined. Structures appear not in one remote location but across three major desert regions: Namibia in Southern Africa, Oman on the Arabian Peninsula, and Saudi Arabia.
These locations stretch thousands of miles apart, suggesting a widespread biological phenomenon predating human civilization by eons.
The geographic distribution raises a critical question: how did the same organism thrive across such distant environments?
Desert Geology’s Blind Spot

For decades, geologists catalogued desert rock formations without noticing these structures. Endolithic—organisms living inside rock—have been studied in modern contexts, but ancient evidence remained overlooked.
Traditional geological surveys focused on larger formations and mineral composition, not microscopic borings.
This gap in understanding left one of Earth’s oldest biological mysteries unexamined until systematic research finally exposed the hidden record.
The Dating Challenge

Confirming the age of these structures proved as complex as finding them. Researchers employed multiple dating methods on surrounding marble and limestone formations to establish a reliable timeline.
Evidence consistently points to a single epoch: between 1 and 2 million years ago, during the Pleistocene era.
This dating places the structures alongside early human ancestors and far predates any known microbial fossil record in arid environments.
The Discovery: Unknown Life Form Identified (Sort Of)

Professor Cees Passchier of Johannes Gutenberg University Mainz announced the finding in February 2025: tube-like structures inside million-year-old marble and limestone, created by an unknown endolithic microorganism.
The structures measure approximately 0.5 millimeters wide and up to three centimeters long, arranged in parallel bands stretching up to ten meters.
Despite detecting biological material within the tunnels, researchers recovered no DNA—leaving the organism’s identity completely unknown.
Namibia’s Unexpected Archive

Namibia’s Namib Desert yielded the initial discoveries approximately fifteen years ago. Passchier’s fieldwork in this remote region first exposed the mysterious burrows embedded in marble formations.
The desert’s harsh, arid conditions preserve ancient rock with remarkable fidelity, creating a natural archive.
Once identified, the Namibian specimens served as a template for recognizing identical structures in distant regions—proof of a phenomenon far larger than any single locale.
Passchier’s Personal Quest

For over fifteen years, Professor Passchier pursued this mystery across continents. His persistence transformed a curious anomaly into a published scientific discovery.
Passchier described the significance of the finding candidly: “What is so exciting about our discovery is that we do not know which endolithic microorganism this is. Is it a known form of life or a completely unknown organism?”
His statement encapsulates the mystery—not knowing becomes the discovery itself.
The Global Carbon Cycle Connection

If this unknown organism still exists today, it carries implications for Earth’s carbon cycle. Endolithic microbes boring through rock participate in bioweathering—the process by which life chemically and physically breaks down minerals.
At a global scale, this activity influences carbon sequestration and atmospheric chemistry.
Understanding an organism that has operated for millions of years could reshape models of how subsurface life affects planetary systems and climate patterns.
Astrobiology’s New Frontier

The discovery opens unexpected doors for extraterrestrial life research. If life thrives inside rock without sunlight on Earth, analogous organisms could potentially exist on Mars or other planets with subsurface rock formations.
NASA and international astrobiology programs now consider endolithic niches as plausible habitats for ancient extraterrestrial microbial life.
The Namibian discovery transforms from a geological curiosity into a template for understanding life’s diversity beyond Earth.
The DNA Absence Conundrum

The most perplexing aspect: no recoverable DNA or genetic material despite clear biological signatures within the tunnels.
Biological material fills the structures—evidence of life—yet genetic traces have vanished entirely. This absence could indicate organism death millions of years ago, or that extreme conditions degraded DNA beyond recovery.
Alternatively, the organism might employ unusual biochemistry incompatible with standard extraction methods. This uncertainty deepens the mystery rather than resolving it.
Scientific Frustration and Opportunity
The inability to identify the organism frustrates researchers while simultaneously energizing investigation. Traditional microbiology relies on DNA sequencing and cultivation—tools rendered useless here.
Yet this limitation creates opportunity: discovering an organism that defies standard identification would represent one of microbiology’s most significant findings.
The scientific community faces an unusual situation: a clear biological phenomenon with no clear biological answer.
International Research Network Mobilizes

Following publication, Passchier’s team called for global collaboration. Specialists from geology, microbiology, paleontology, and astrobiology worldwide are now examining the discovery.
Universities in Germany, the United States, and Australia have launched follow-up investigations. This represents a rare moment where a single paper catalyzed coordinated international scientific effort.
The structures themselves become a collaborative research platform.
Oman and Saudi Arabia Confirm the Pattern

Subsequent fieldwork in Oman and Saudi Arabia revealed identical structures in limestone formations. This geographic replication transformed the Namibian discovery from an isolated anomaly into a pattern.
The consistency across continents and rock types strengthens the hypothesis of a single, widespread organism.
Regional geological differences suggest the microorganism adapted to varied mineral compositions and climate conditions—evidence of remarkable biological versatility.
Dating the Organism Indirectly

Researchers cannot directly date the organism itself—it left no datable remains. Instead, they dated the host rock using radiometric methods and stratigraphic analysis.
This indirect approach creates temporal boundaries but not precise timing. The 1-2 million-year range reflects measurement uncertainty inherent to ancient rock dating.
Narrowing this window could unlock information about when the organism thrived, whether extinction occurred, and if survival persists today.
The Survival Question Looms

Does this organism still exist? Neither surface exploration nor deep drilling has recovered living specimens. Rock formations younger than one million years show no equivalent structures.
This absence suggests either extinction or migration to environments scientists haven’t yet examined. The possibility that it survives somewhere undetected adds urgency to the investigation.
If alive, finding it could answer decades of questions about ancient life and planetary subsurface ecosystems.
Scientific Ethics Implications

This discovery raises novel questions about scientific naming and taxonomy. How do researchers classify organisms with no DNA, no living examples, and no observable behavior?
International scientific bodies may need to revise classification standards to accommodate this unprecedented situation.
The discovery also highlights gaps in paleontological funding and exploration—how many other ancient microorganisms remain undiscovered in Earth’s rocks?
Desert Ecosystems Reconsidered

The finding reshapes understanding of desert subsurface ecology. If endolithic organisms thrive in arid rock, entire ecosystems exist invisible to surface observation.
Desert regions once considered lifeless now appear to host complex microbial communities. This reframing affects conservation policy, groundwater management, and ecological surveys.
Deserts may harbor far greater biological diversity than previously acknowledged—requiring revised approaches to environmental assessment and protection.
Climate and Geochemical Implications

Endolithic boring affects rock chemistry and weathering rates—factors influencing long-term climate patterns. A microorganism active for two million years has participated in planetary-scale biogeochemical cycling.
Understanding its mechanisms could illuminate how life influences rock dissolution, mineral availability, and soil formation.
These processes connect to carbon budgets and weathering rates critical to climate science. The organism becomes a key player in Earth system dynamics.
The Culture Shift: Life’s Infinite Forms

This discovery embodies a philosophical shift in biology: life’s forms and niches far exceed human experience.
An organism thriving silently inside rock for millions of years, leaving barely detectable traces, symbolizes nature’s hidden complexity. It challenges assumptions about what constitutes recognizable life and where life can exist.
As humanity explores potential extraterrestrial life, this humble microorganism serves as a humbling reminder—the most profound discoveries may come from Earth itself.
What Comes Next: The Open Mystery

The 2-million-year-old tunnels remain fundamentally mysterious. Their discoverer, their biology, their modern fate—all questions without answers. Yet mystery itself drives science forward.
Passchier’s work opened a new chapter in microbiology: the study of life forms that defy conventional identification. Future research will hunt for living descendants, decode chemical signatures, and expand the search to other continents.
The desert has revealed its secret but not its source—and that revelation may prove science’s most valuable discovery.
Sources:
Geomicrobiology Journal – “Subfossil Fracture-Related Euendolithic Micro-burrows in Marble and Limestone” – February 27, 2025
SciTechDaily – “Strange Million-Year-Old Rock Tunnels Found in Africa” – April 3, 2025
Forbes – “Traces In Rocks Hint At The Existence Of Unknown Organism” – March 24, 2025
Johannes Gutenberg University Mainz – Press Release: “Unknown microorganisms used marble and limestone as a habitat” – March 18, 2025
The Microbiologist – “What is eating my rocks? A possible novel biological niche inside limestone” – May 18, 2025
Science Daily – “Unknown microorganisms used marble and limestone as a habitat” – March 19, 2025
Phys.org – “Unusual desert rocks suggest unknown microorganism that lived inside marble and limestone” – March 19, 2025